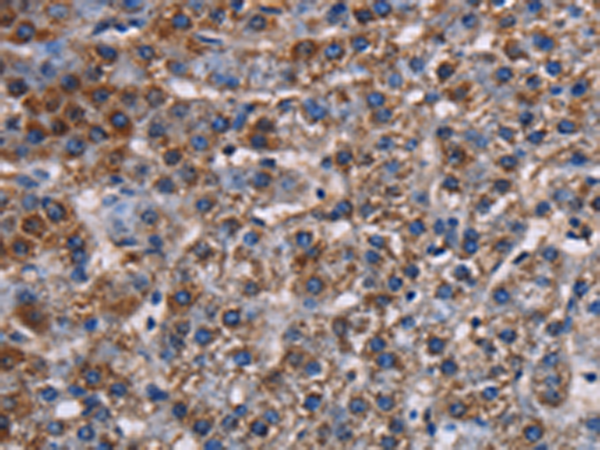
一抗

技術(shù)規(guī)格
|
Background: |
This gene encodes one of the members of the superfamily of potassium channel proteins containing two pore-forming P domains. The product of this gene has not been shown to be a functional channel, however, it may require other non-pore-forming proteins for activity. |
|
Applications: |
ELISA, IHC |
|
Name of antibody: |
KCNK1 |
|
Immunogen: |
Fusion protein of human KCNK1 |
|
Full name: |
potassium channel, subfamily K, member 1 |
|
Synonyms: |
DPK; HOHO; K2P1; KCNO1; TWIK1; K2p1.1; TWIK-1 |
|
SwissProt: |
O00180 |
|
ELISA Recommended dilution: |
2000-5000 |
|
IHC positive control: |
Human lung cancer |
|
IHC Recommend dilution: |
50-200 |

 購物車
購物車 幫助
幫助
 021-54845833/15800441009
021-54845833/15800441009